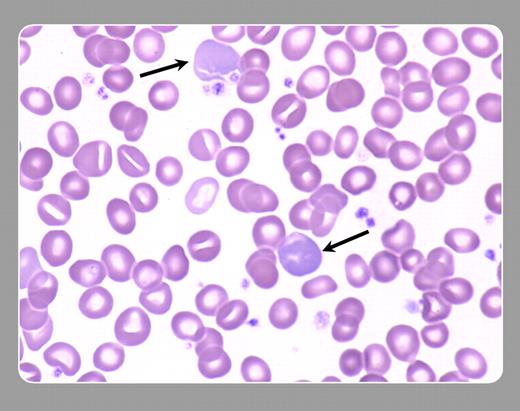
Peter Maslak, Memorial Sloan-Kettering Cancer Center

Polychromatophilic red cells are marked by the arrows. These cells are larger and lack the characteristic central pallor of more mature erythrocytes. With standard stains, they have a classic blue-gray appearance that results from the residual RNA in the cells. Also found on this blood smear are several stomatocytes.FIG1
Many Blood Work images are provided by the ASH IMAGE BANK, a reference and teaching tool that is continually updated with new atlas images and images of case studies. For more information or to contribute to the Image Bank, visit www.ashimagebank.org.
Copyright © 2005 by The American Society of Hematology
2005
Peter Maslak, Memorial Sloan-Kettering Cancer Center
This feature is available to Subscribers Only
Sign In or Create an Account Close Modal